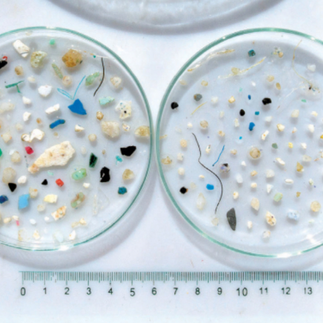

Microplastic: Comprehending this new devil on the rise!
- Global-Gazette

- Feb 8, 2025
- 5 min read
Sourosree Lahiri
The 21st century, the high-tech monarch, now finds itself at the mercy of a new devil predator. A monstrous, creeping menace that lurks in our air, water, food, and even our own bodies. A crisis we never saw coming, yet one we created ourselves.
YESSSSS! I’m talking about MICROPLASTICS!
This satanic spawn of modern convenience is growing, multiplying, and infiltrating every aspect of life on Earth. And who is responsible? US—humans! We engineered this catastrophe, and now we are gasping for solutions before it’s too late.
Plastic: A Blessing Turned Curse
Since the 1950s, plastic has been our trusted companion. It revolutionized industries, making everything cheaper, stronger, and more convenient. From clothes and transportation to cleaning supplies and food packaging, plastic became an inseparable part of modern life.
But just as we started realizing the horrifying consequences of plastic pollution, a newer, deadlier form emerged MICROPLASTICS & NANOPLASTICS. And we are already trapped in their vicious cycle.
What Exactly Are Microplastics?
The United Nations Environment Programme (UNEP) defines them as polymer-based particles measuring 5 mm or less. These are either:
🔹 Primary microplastics – Manufactured for use in products like cosmetics, textiles, and industrial abrasives.
🔹 Secondary microplastics – Formed when larger plastic items degrade under sunlight, weathering, or friction.
They are in your face wash. Your clothes. The air you breathe. The water you drink. The food you eat. There is NO escaping them.
Where Do They Come From?
The sources of these microscopic demons are endless, but let’s expose the biggest culprits:
1)Primary Microplastics:
• City dust and industrial emissions
• Synthetic textiles shedding microfibers every time we do laundry
• Tire wear from vehicles, releasing plastic dust into the air
• Plastic microbeads in personal care products (yes, your “exfoliating” face scrub is part of the problem!)
2)Secondary Microplastics:
• Plastic bottles, wrappers, and bags degrading into microfragments
• PET bottles breaking down under UV radiation, leaking toxins into water
• COVID-19 waste (masks, PPE kits, online shopping packaging) adding millions of tons of plastic waste into the environment And the worst part? They don’t just disappear. They persist for centuries, wreaking havoc on ecosystems and human health.
Source: Manshoven et al., Eionet Report-ETC/CE 1, 2022
The Damage: How Microplastics Are Destroying Us
Think microplastics are just another pollution problem? Think again. They are everywhere, and they are killing us—slowly and silently.
Oceans are drowning in plastic – Every year, 1.15 to 2.41 million tons of plastic waste enter our seas through rivers (Lebreton et al. 2017). Marine creatures ingest them, and we, in turn, consume these contaminated seafood.
Source: Pohl et al., 2020
We are breathing in plastic – Studies show indoor air contains more microplastics than outdoor air (Dris et al., 2017). Yes, you are inhaling plastic particles as you read this.
You are eating plastic – A recent study revealed that humans ingest the equivalent of a credit card in plastic every week.
Microplastics are linked to cancer, hormonal imbalances, respiratory diseases, and reproductive health issues. They don’t just pollute; they invade our cells, disrupt biological functions, and poison us from within.
Source: Bhuyan, 2022
So How Do We Solve This Menace?
So how do we solve the gravity of this menace? Solutions are many. But it requires three key things:
Awareness – People need to understand the magnitude of the problem.
A Sensitive Heart – We must feel responsible for the damage we have done to our planet.
Conscious Efforts – Each one of us must take deliberate actions to save Mother Earth.
Can we stop it? The answer—YES. But only if we act NOW!
Here’s how we can fight back—as individuals, industries, and policymakers.
1. Ban & Regulate Plastic Use
Ban Microbeads in Cosmetics – Several countries have already done this, but global enforcement is a must.Extended Producer Responsibility (EPR) – Companies need to take responsibility for their plastic waste.Strict Waste Management & Recycling Systems – To prevent plastic leakage into nature.
2. Technological Innovations to Fight Back
Develop Biodegradable Plastics – Alternatives like cornstarch and algae-based plasticscan replace synthetic materials.Microplastic Filtration Systems – Washing machines, water treatment plants, and industries must integrate microplastic filters.Plastic-Eating Microbes – Scientists are researching bacteria that can consume and break down plastic naturally.
Source: www.twitter.com
3. Conscious Transformation in Behaviour both at the Individual & Corporate level
Conscious package opening: Every time we open a milk/or chips packets let us do so with separating the small pieces. Quoting Chairperson Adamya Chetana, Tejaswini Anthakumar “ if all of us open the milk packet without separating the piece we in Bengaluru alone can stop 50,00,000 small plastic pieces getting in the garbage. Small pieces cannot be, recycled”.
Stop Using Plastic Bags – Carry a reusable cloth bag instead.
Say No to Single-Use Plastics – Ditch plastic straws, cutlery, and disposable water bottles.Choose Natural Fabrics – Opt for cotton, hemp, or linen over polyester and nylon.
Source: a) www.amazon.in , b) www.shutterstock.com
Big Businesses Must Adopt Biodegradable Packaging – Companies like Zomato, Swiggy, and Amazon need to ditch plastic and switch to sustainable alternatives.
4. Spread Awareness & Research
Educate and Inform – The more people know, the more they act.Invest in Scientific Research – Advanced research is the urgent need of the hour in order to understand the sources, pathways and innovate solutions seeking how microplastics spread and how they can be eliminated.Community-Led Cleanups – Beach, river, and city cleanups can prevent plastic from reaching water bodies and will invariably reduce the formation of microplastics.
The Final Battle: We Are Running Out of Time!
This isn’t just an environmental crisis. This is a war.
A war against a monster we created. A war against plastic pollution, corporate negligence, and careless consumption habits.
The most effective solutions will happen at the beginning of the plastic life cycle—not once it has already polluted our planet. We need to:
✔️ Hold industries accountable
✔️ Change the way we use plastic
✔️ Adopt sustainable alternatives NOW
The fight against microplastics is a fight for our own survival. Will we rise to the challenge, or will we let this invisible devil consume our future?
So how to solve the gravity of this menace. Solutions are many. It requires awareness and a sensitive heart and making conscious efforts to save mother Earth.
The time to act is NOW. The world won’t wait.
What’s your take on microplastic pollution? Share your thoughts below!
References:
Halle et al., Journal of Geophysical Research: Oceans, 2020, 125, 1.
Zetler et al., Environmental science & technology, 2013, 47, 7137.
Dris et al., Environmental pollution, 2017 221,453 :
Lebreton et al. 2017, Nature Communications, 2017, 8, 1:
Cozar et al., Science Advances, 2017, 3,1.
Haque et al., Journal of Cleaner Production, 2022, 36, 133027.
Aragaw, SN Applied Sciences, 2021, 3, 1.
Bermudez et al., Marine Pollution Bulletin, 2021, 170, 112622.
Saling et al., 2020, The International Journal of Life Cycle Assessment, 2020, 25, 2008.
Zao et al., Water, 2022, 14. 2403.
Issac et al., Environmental Science and Pollution Research, 2021, 28, 19544.
Lebreton et al., Nature Communications, 2017, 8, 1:
Pohl et al., Environmental science & technology, 2020, 54, 4180.
Courtene-Jones et al., Marine Pollution Bulletin, 2020, 154, 111092
Waller et al., Science of The Total Environment, 2017, 598, 220.
Bhuyan, Frontiers in Environmental Science, 2022, 10, 1.

It’s high time to think and debate more.
Thank you for writing this masterpiece.
A poem
Microplastic—tiny yet vast in destruction,
A speck so small, yet a grave disruption.
It poisons the waters, the earth, the air,
Yet who truly stops to care?
We chase beauty, we crave a glow,
Ignoring the cost the oceans know.
What we wear, what we use—so refined,
Yet blind to the suffering left behind.
We dream of a world that’s pure and green,
But who will build it? Who will intervene?
It’s you, it’s me—our choice, our power,
To rethink habits in this crucial hour.
So pause, reflect, read what’s inside—
Before the world is swept by the rising tide.
~Shama ~